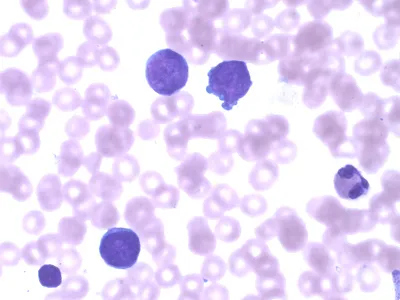
Image of megakaryoblastic cells from a patient with Down syndrome acute megakaryoblastic leukemia.

Many of the same transcription factors and associated epigenetic cofactors involved in normal hematopoiesis are mutated in various human leukemias or pre-leukemic conditions. These typically occur as early events in the disease process, providing a “window of opportunity” to intervene in order to reduce the risk of full transformation to leukemia. A major focus of our work in the Cantor Lab is on further understanding the mechanisms by which mutations in these factors contribute to leukemogenesis, and to translate this information into new therapies to prevent leukemia from developing in at-risk individuals.
In particular, we study a number of leukemia predisposition disorders associated with germline and somatic mutations in normal hematopoietic transcription factors, including RUNX1, GATA1, GATA2, and certain ETS factors. Current focus areas of basic/translational research in the Cantor lab on leukemogenesis include:
- Understanding the mechanisms by which RUNX1 and GATA2 mutations predispose to clonal hematopoiesis and leukemia development
- Identifying small molecules to enhance the residual wild type RUNX1 and GATA2 protein activity in pre-leukemic disorders associated with heterozygous mutations in the RUNX1 and GATA2
- Understanding how leukemia-associated mutations in transcriptional regulators alter 3D chromatin structure
- Understanding the mechanisms by which GATA1 mutations lead to Down syndrome Transient Myeloproliferative Disorder and Megakaryoblastic Leukemia
- Understanding molecular mechanisms underlying development of non-MLL rearranged therapy-related myelodysplastic syndrome (t-MDS).
- Examining the role of RUNX1 downstream of activated PTPN11/RAS signaling in Juvenile Myelomonocytic Leukemia, and developing RUNX1 inhibitors as potential novel therapeutics for this disease